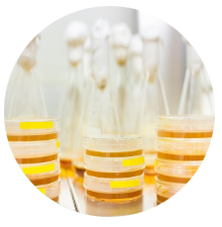

가이아바이오는
깨끗하고 건강한 환경을 만들기 위해
미생물을 활용한 친환경 솔루션을 제공합니다
현재 우리는 광범위하게 확산되는 자연의 자정능력 회손, 생태계 파괴의 문제를 직면하고 있습니다.
자연 그 자체의 모습처럼 자연스럽고 깨끗한 미생물은
다양한 물질의 발효, 숙성, 분해를 도와
토양을 개선하고 유해 물질과 악취 가스를 분해하여 오염된 환경을 복원시키며 생태계의 균형과 보존을 돕습니다.
유한회사 가이아바이오는
다양한 환경·세밀한 적용 분야에 최적화된 미생물을 배양·생산하여
지구 환경 보호와
미래 청정환경 구축에 기여하고자 합니다.
유한회사 가이아바이오
대표이사 하성해
-
 분야별 최고의
분야별 최고의
특성을 가진 종균
-
분야별 종균에
분야별 종균에
최적화된 배양배지
-
 지능형 무균
지능형 무균
미생물 배양시설
-
 미생물 제품의
미생물 제품의
글로벌 품질 경쟁력